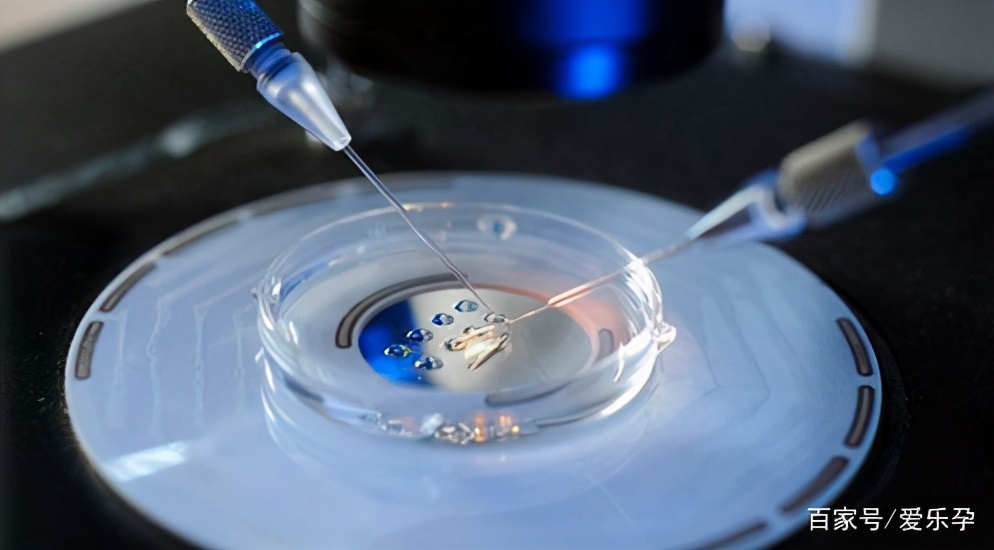
一般试管婴儿取几个卵正常,试管婴儿都是先移植最好的胚胎吗

最理想的状况,取卵和取精是需要同时进行的。试管婴儿是将卵子与精子取出,在体外结合受精并培育成胚胎,再将胚胎移植到母体子宫内完成着床,以达受孕目的。
这样一方面当然保证精子和卵子的新鲜,受精率以及配成胚胎更加有保障;另一方面是夫妻双方一同到医院,可以相互鼓励和给予精神上的支持,心态也会更加平和,对取卵、取精操作也会有益。

男性在取精前需要有哪些准备?
在取精的前5-7天,男方需排一次精,之后不可以再排精,也就是禁欲,注意一定不要让精液排出来。
此外,男方还得远离烟、酒、刺激性食物等,确保作息规律,为产生优质的精子做好充足准备。
精液的健康决定了如何取精!
如果男方有正常的射精,需要在女方取卵当天,男方到医院进行手淫取精,这个过程和精液常规检查时取精过程类似。
如果男方为无精子症,在试管婴儿之前已经进行诊断,需要在取卵的当天进行手术取精。
如果男方是逆行射精,则需要根据医生的指导来取精。

取卵取精不能同时进行怎么办?
如果男方确实因为特殊原因或者本身精子质量因素不能在取卵日取精,为了保证试管周期的顺利进行,也可以在女性取卵日之前进行取精。精子取出后进行冷冻保存,待女性取卵当日进行解冻用以受精。
说完取精的事儿,很多女性朋友就会问了“卵子是怎样取出来的?” “取卵是不是很痛吗?”“全麻会不会影响卵子质量?”“ 取卵是不是越多越好?”
卵子是怎样取出来的?
取卵术是在B超下引导经阴道穿刺的手术,然后在负压吸引下抽吸干净卵泡液,并迅速移交给实验室于显微镜下查看、检出卵子。
手术时间大约5~15分钟。当然这不是绝对的,具体的时间还是要视乎卵泡的多少和卵巢的位置而定。少数取卵困难的朋友,取卵时间会比较长,和卵泡数也会不成正比。

取卵很痛吗?
取卵手术是在阴道B超引导下进行的,过程中会有疼痛感的。做过取卵手术的妹子有的说很痛,有的说有一点疼,这跟个体的疼痛阈值有关,也和心理因素有关。

什么是无痛取卵?
无痛取卵术即静脉麻醉取卵术,由专业的麻醉医生通过静脉推注小剂量的镇静镇痛药物,亲爱的您在取卵过程中就睡着啦!手术结束即可自行清醒,对手术过程无记忆。
适用于:
①惧怕疼痛,无法忍受取卵操作者;
②恐惧焦虑者;
③卵泡监测时卵巢位置较高预计穿刺取卵困难者;
④卵泡数目较多,估计取卵时间较长者。
术后*醉药麻**药效过后也会有疼痛的感觉,不过这种感觉很轻微,一般类似于抽血或者打针那种疼痛。

麻醉会影响卵子质量吗?
不会。
因为取卵打麻醉一般用的是静脉麻,一般不会对身体产生伤害,也不会影响卵子质量。
取卵是不是越多越好?
取卵并不是数量越多越好。
获卵数与患者的年龄、基础FSH水平、窦卵泡数及卵巢对卵巢对控制性促排卵(COH)的反应程度有关,每个人的情况都会不同,取卵并不是只看数量没也需要看咱们的质量。
先取精还是先取卵,能同一天一起进行最好一起,有其他原因不能同一天的,根据双方的身体检查跟医生沟通好,医生会给出你专业的建议。
注意:
文章目的是提供一般的健康信息,不能代替任何个人的医学诊断和治疗,个人医疗问题,就诊问题请私信爱乐孕或在评论区留言。